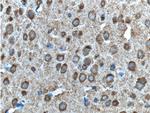
ADRA1B Antibody in Immunohistochemistry (Paraffin) (IHC (P))

Search
Proteintech
ADRA1B Polyclonal Antibody
{{$productOrderCtrl.translations['antibody.pdp.commerceCard.promotion.promotions']}}
{{$productOrderCtrl.translations['antibody.pdp.commerceCard.promotion.viewpromo']}}
{{$productOrderCtrl.translations['antibody.pdp.commerceCard.promotion.promocode']}}: {{promo.promoCode}} {{promo.promoTitle}} {{promo.promoDescription}}. {{$productOrderCtrl.translations['antibody.pdp.commerceCard.promotion.learnmore']}}
产品信息
19776-1-AP
种属反应
宿主/亚型
分类
类型
抗原
偶联物
形式
浓度
规格
纯化类型
保存液
内含物
保存条件
运输条件
产品详细信息
This antibody is specific to ADRA1B.
靶标信息
The alpha-1b adrenoceptor is an Adrenergic Receptor that causes contraction of smooth muscle cells and thereby controls vascular tone, blood pressure, and accelerates the development of atherosclerosis. Decreased alpha-1b adrenoceptor is associated with benign prostatic hyperplasia (BPH). This adrenergic receptor also acts as a proto-oncogene when transfected into cell lines where constitutive activation of the receptor induces neoplastic transformation. The alpha-1b adrenoceptor has been documented in adrenal, aorta, blood, various brain regions, eye, heart, kidney, liver, prostate, spinal cord, and spleen. ESTs have been isolated from kidney (normal and cancer) and lung carcinoma libraries.
仅用于科研。不用于诊断过程。未经明确授权不得转售。
生物信息学
蛋白别名: ADA1B; Adrenergic alpha 1B- receptor; adrenergic receptor, alpha 1b; adrenergic, alpha-1B-, receptor; alpha 1B-adrenoceptor; alpha 1B-adrenoreceptor; Alpha-1B adrenergic receptor; Alpha-1B adrenoceptor; Alpha-1B adrenoreceptor; alpha1B-adrenergic receptor
基因别名: [a]1b; ADRA1; ADRA1B; ALPHA1BAR
UniProt ID: (Human) P35368
Entrez Gene ID: (Human) 147, (Rat) 24173, (Mouse) 11548